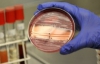
Бактерия E.сoli уже убила 50 человек

В Чехии смертельно опасная бактерия E.coli, вызывающая кишечную инфекцию, обнаружена в бутылках с минеральной водой. Государственная сельскохозяйственная и продовольственная инспекция срочно распорядилась изъять воду Aquila Aqualinea из магазинов и предупредила покупателей о том, что крупная партия этой воды может представлять опасность для здоровья.
Компания-производитель воды Karlovarske mineralni vody изъяла из оборота 33 тыс. бутылок и попросила покупателей проверить купленную ранее минеральную воду - на бутылке указан срок годности "до 20.05.2012".
В Европе от кишечной инфекции, вызванной бактерией E.coli, уже погибли более 50 человек. Изначально вспышка была зафиксирована на севере Германии. Сначала предполагалось, что переносчиком опасных бактерий являются огурцы из Испании, но это предположение не подтвердилось. Затем специалисты предполагали, что источником инфекции могла стать ферма в Нижней Саксонии.
В четверг медики выдвинули версию, что зараженные бактерией E.coli семена могли быть ввезены в Европу из Египта в 2009-2010 годах. Но и эта информация позднее была опровергнута египетским министерством сельского хозяйства.
В начале июня специалисты Европейского центра по контролю и профилактике заболеваний (ECDC) сообщили, что причиной заболеваний является редкий тип E.сoli: этот мутировавший штамм ранее не был известен, он устойчив ко многим антибиотикам.

Комментарии
3